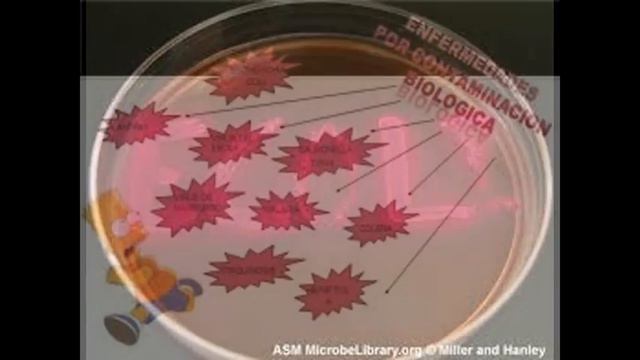
presentación: escherichia coli смотреть онлайн

Автор / Канал: Секреты завтрашнего дня Страница 9

Прикольная козочка кушает травку

Rigmor of Bruma - Reboot | Ригмор из Брумы - Перезагрузка SE

Cách sửa lỗi Windows Search không hoạt động Windows 11 - 10

Прохождение растения против зомби (часть 3. Глава- день. Уровни 9-10)

Ольга Ларина – завотделом регистрации места жительства исполкома Покровского райсовета

5 ЛЕТ ТЮРЬМЫ ЗА ЧИТЫ В WORLD OF TANKS!

VLOG:ДЕЛАЕМ🍕ПИЦЦУ🍕/ИДЁМ В АШАН\

-DOTA 2-Что это такое?! Баги или фейлы или профессиональная игра?!

Ипотека 6,5% - время покупать? Мнение экспертов

Радиология

My Feet are Killing Me: The GROSSEST Moments of 2021! SUPER GROSS!! (Part 4)
![[meme] [что такое добрата? ] [ есть маленькая ошибка] смотреть онлайн [meme] [что такое добрата? ] [ есть маленькая ошибка] смотреть онлайн](https://pic.rtbcdn.ru/video/60/a7/60a706edab833aaf9130b4d89d1000e4.jpg)
[meme] [что такое добрата? ] [ есть маленькая ошибка]
presentación: escherichia coli

Сьерра-Леоне vs Папуа новая Гвинея

Guilds: Official Sea of Thieves Season Ten Deep Dive

Сравнение CRODO c DAO Maker

Архетипы в стиле: ЗАБОТЛИВЫЙ, ТВОРЕЦ, ПРАВИТЕЛЬ спикер: Лилия Ерофеева

#вязальныйвлог Итоги февраля 2024г, покупки для создания бебибоксов, новые работы #вязаниекрючком

Так и было всё...🥲

Что под одеждой у Кристал? What is under the clothes of Crystal?

LE150326 003 Медицинский директор концерна Bayer в России

Dark Souls 3 / Dark Souls III - Trailer

СЛОВА НАД КОТОРЫМИ СТОИТ ЗАДУМАТЬСЯ.ПОСЛУШАЙ ДО КОНЦА

Формы эксплуатации человека человеком
За каждым успешным каналом стоит личность, идея и сотни часов кропотливого труда. Если вы здесь, значит, автор «Секреты завтрашнего дня» уже сумел зацепить ваше внимание своим уникальным стилем или подачей. А мы на RUVIDEO позаботились о том, чтобы вы могли изучить весь архив его работ в максимально комфортных условиях — без лишней суеты и преград.
Почему за работами канала «Секреты завтрашнего дня» так интересно наблюдать? Всё просто: это честный контент, который находит отклик в сердцах зрителей. На нашем ресурсе вы можете смотреть онлайн все видео любимого автора бесплатно и в хорошем качестве. Нам важно, чтобы вы видели каждую деталь и слышали каждый нюанс, поэтому мы используем только стабильные плееры из открытых источников Rutube.
Следите за новинками канала, пересматривайте старые шедевры и открывайте для себя новые грани творчества «Секреты завтрашнего дня». Мы постоянно обновляем ленту, чтобы у вас под рукой всегда были самые свежие выпуски. Никаких сложных регистраций — только вы и творчество, которое вдохновляет. Приятного вам путешествия по миру авторского контента на RUVIDEO!
Видео взято из открытых источников Rutube. Если вы правообладатель, обратитесь к первоисточнику.